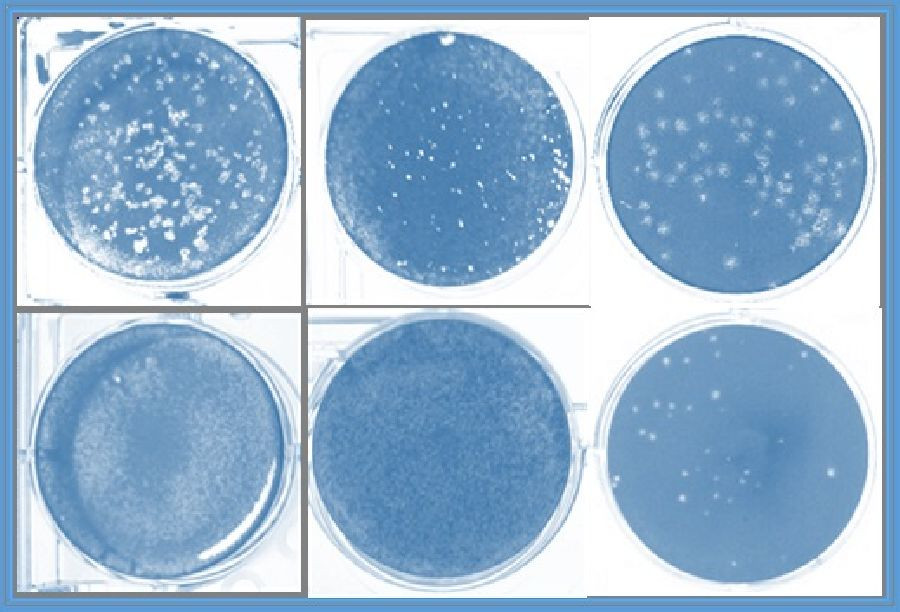

Investigadores del CSIC descubren que moléculas sintéticas de ARN inducen una respuesta inmune para el Covid-19
Un grupo de investigadores del Consejo Superior de Investigaciones Científicas (CSIC) en el Centro de Biología Molecular Severo Ochoa (CSIC-UAM) y en el Instituto Nacional de Investigación y Tecnología Agraria y Alimentaria (INIA) han descubierto que unas moléculas sintéticas de ARN no codificante derivadas de un genoma viral (del virus de la fiebre aftosa) desencadenan una respuesta inmune que bloquea la infección por SARS-CoV-2 y por otros coronavirus animales y humanos.
Los resultados del estudio, desarrollado en el marco de la Plataforma Temática Interdisciplinar Salud Global, del CSIC, han sido publicados en la revista 'Frontiers in Immunology'.
Los experimentos con estas moléculas sintéticas de ARN no codificante se han llevado a cabo frente a un coronavirus catarral humano (HCoV-229E) y al SARS-CoV-2 en células humanas de pulmón y de colon, así como frente a un coronavirus porcino (TGEV). "Estas moléculas actúan imitando señales genéticas propias de patógenos virales y activan en las células una potente respuesta inmune innata", detalla la investigadora Margarita Sáiz, del Centro de Biología Molecular Severo Ochoa.
"Nuestros resultados indican que el desarrollo de nuevas estrategias terapéuticas combinadas basadas en ARN podría prevenir la infección por estos virus y por otros nuevos virus emergentes", explica Sáiz.
En la actualidad, las opciones terapéuticas que utilizan antivirales de acción directa para pacientes con Covid-19 son limitadas y basadas en compuestos de actividad muy específica diseñados para interferir en la replicación de su genoma o en la funcionalidad de determinadas proteínas.
La investigadora asegura que estos nuevos hallazgos "aportan una prueba de concepto de la eficacia in vivo de estas moléculas sintéticas de ARN no codificante para el tratamiento de enfermedades producidas por coronavirus". A diferencia de los antivirales usados actualmente, dirigidos de manera muy específica a determinadas dianas, "estas moléculas activarían una respuesta antiviral de amplio espectro capaz de prevenir la infección o limitarla en un contexto terapéutico."
Asimismo, el modo de acción de estas moléculas permite la combinación con otros compuestos específicos que puede resultar en formulaciones sinérgicas frente a SARS-CoV-2. "Su uso podría ser también de utilidad en el tratamiento de pacientes con Covid-19 persistente", añade Sáiz.
El trabajo ha sido financiado en parte por la PTI Salud Global del CSIC y se ha realizado en colaboración con dos grupos de investigación del INIA, lo que ha permitido al equipo del CBMSO el acceso a los ratones transgénicos específicos y realizar ensayos de infección in vivo en el animalario de alta seguridad biológica del CISA-INIA.
Sé el primero en comentar